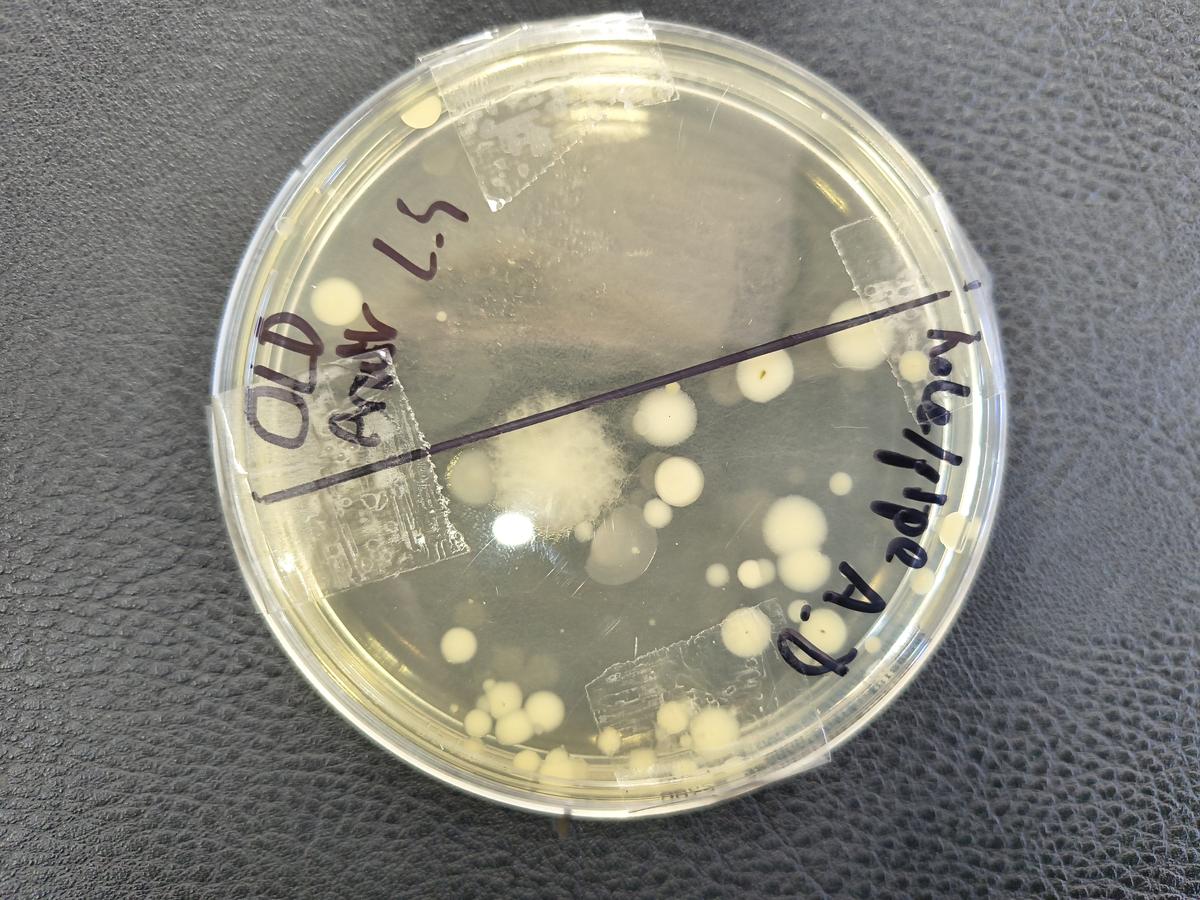
Gallery Image

Science
Year 8

Science
Year 8
Our Yr 8's spent a whole day at KIOSC as part of their science subject recently. They participated in the three sessions of the “Sustainable Futures” program which is designed to explore the possibilities of the next 25 years in the face of escalating climate challenges.
They became budding architects, applying the fundamental scientific principles of conduction, convection, and radiation to create a sustainable passive house to minimize heat intake during daylight hours.




Through experimentation and creative problem-solving, students learnt how to strategically utilize these concepts to design a comfortable and energy-efficient living space, fostering a deeper understanding of sustainable building practices.


In the second session they utilised diverse energy sources, including wind, solar, biofuel, and hydrogen, to gather and analyse empirical data to explain the efficacy of various energy sources.


The final session focused on developing the skills necessary to implement robotic solutions for space-efficient food production systems, providing insight into future agricultural practices such as automated vertical farming.


Year 8 students have been quite busy at school as well; putting their science skills to the test by investigating which areas around the school might harbour the most bacteria. Using sterile swabs and agar plates, students collected samples from various locations — from classroom desks to door handles — to grow and observe bacterial colonies.

The investigation helped them understand how microorganisms spread and the importance of hygiene in our everyday environment. It’s been a fascinating and eye-opening experience that combined hands-on experimentation with real-world learning.
Year 8's have now moved on to learning about the different body systems.
Research shows that parental involvement (including being aware of what is being learned) is positively associated with both academic achievement and social/emotional wellbeing of the children. So, we encourage you to ask your child about their science lessons and make these conservations a part of your routine. For further information please follow the link below:
Benefits of Parent Involvement
Ozlem Alpcan
Science